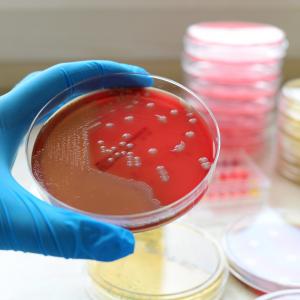
Bakterije i antibiotici danas

Antibiotici - danas liječe, sutra možda neće!
Kampanja o antibioticima
Zavod za javno zdravstvo Dubrovačko-neretvanske županije medijskom kampanjom priključuje se obilježavanju Svjetskog tjedna svjesnosti o antibioticima i Europskog dana svjesnosti o antibioticima.
Antimikrobna rezistencija (otpornost) je ozbiljna prijetnja javnom zdravlju. O njenom razvoju i porastu širom svijeta govori se već dugi niz godina. Antibiotici polako gube bitku pred ubojitim i sve otpornijim bakterijskim vrstama, što rezultira lošijim ishodima liječenja infekcija osobito bolničkih.
Ipak, rastuća rezistencija bakterija na antibiotike može se usporiti kritičkim propisivanjem antibiotika ali i osobnim odgovornim ponašanjem.
Godine 2019. Zavod za javno zdravstvo Dubrovačko-neretvanske županije pokrenuo je medijsku kampanju "Antibiotici - danas liječe, sutra možda neće!"